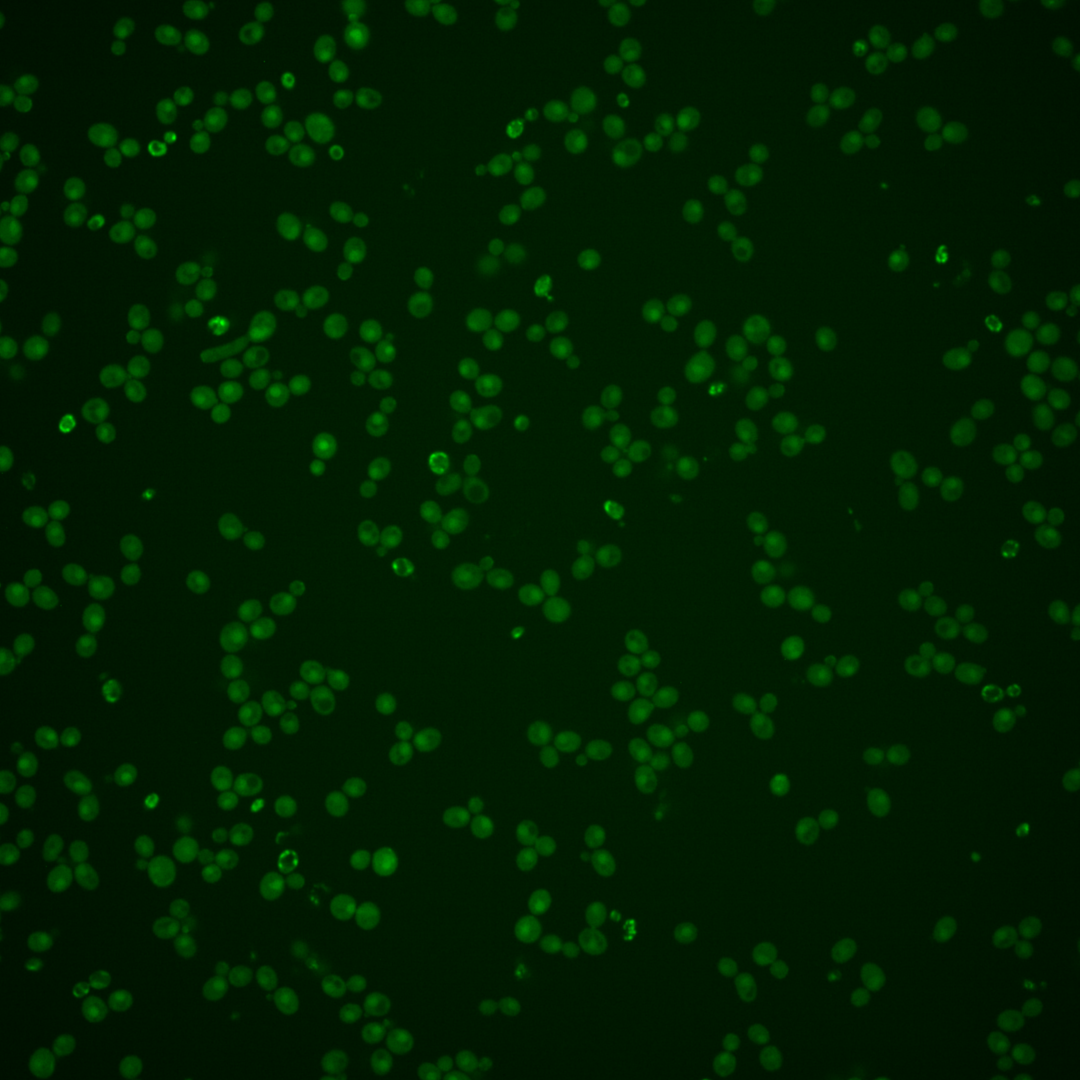
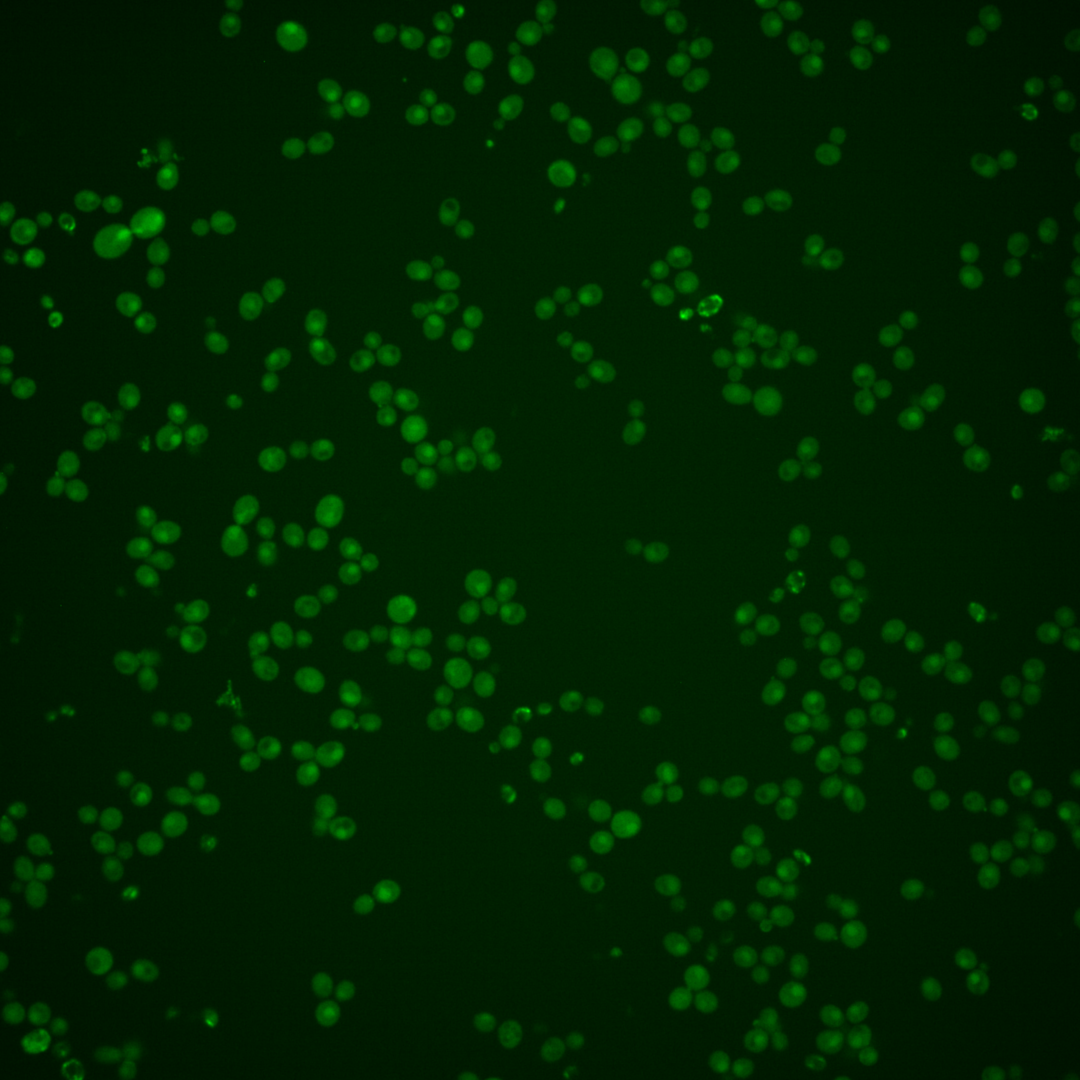

| Standard name | |
|---|---|
| Human Ortholog | |
| Description | Protein with a role in regulating Swe1p-dependent polarized growth; involved in maintaining Cdc55p in the cytoplasm where it promotes mitotic entry; involved in mitotic exit through Cdc14p regulation; interacts with silencing proteins at telomeres; has a role in Bcy1p localization; implicated in mRNA nuclear export; ZDS1 has a paralog, ZDS2, that arose from the whole genome duplication |
Micrographs




















































































Sub-cellular Localization
Yeast GFP Assignment
Protein Abundance
Localization Change
External localization resources
| ensLOC | DeepLoc | |||||||||||||||||||||||
|---|---|---|---|---|---|---|---|---|---|---|---|---|---|---|---|---|---|---|---|---|---|---|---|---|
| Localization | WT1 | WT2 | WT3 | RAP60 | RAP140 | RAP220 | RAP300 | RAP380 | RAP460 | RAP540 | RAP620 | RAP700 | HU80 | HU120 | HU160 | rpd3Δ_1 | rpd3Δ_2 | rpd3Δ_3 | WT1 | WT2 | WT3 | AF100 | AF140 | AF180 |
| Cortical Patches | 18 | 2 | 13 | 4 | 16 | 1 | 8 | 4 | 1 | 8 | 3 | 2 | 0 | 0 | 0 | – | 7 | 3 | 16 | 1 | 28 | 3 | 8 | 11 |
| Bud | 11 | 4 | 14 | 8 | 21 | 11 | 25 | 28 | 30 | 37 | 25 | 31 | 0 | 0 | 1 | – | 5 | 3 | 10 | 3 | 6 | 2 | 4 | 9 |
| Bud Neck | 2 | 0 | 2 | 0 | 5 | 3 | 3 | 3 | 0 | 0 | 0 | 0 | 1 | 1 | 0 | – | 7 | 0 | 8 | 1 | 16 | 5 | 9 | 11 |
| Bud Site | 1 | 1 | 0 | 0 | 0 | 0 | 0 | 5 | 0 | 2 | 2 | 2 | 0 | 0 | 0 | – | 0 | 0 | – | – | – | – | – | – |
| Cell Periphery | 26 | 0 | 37 | 41 | 33 | 23 | 43 | 39 | 28 | 43 | 62 | 51 | 14 | 14 | 22 | – | 18 | 17 | 8 | 0 | 25 | 4 | 7 | 8 |
| Cytoplasm | 173 | 46 | 314 | 309 | 501 | 360 | 569 | 726 | 449 | 492 | 366 | 426 | 115 | 115 | 167 | – | 411 | 223 | 164 | 59 | 229 | 76 | 150 | 231 |
| Endoplasmic Reticulum | 4 | 2 | 1 | 0 | 1 | 4 | 8 | 4 | 5 | 10 | 6 | 3 | 1 | 1 | 2 | – | 27 | 15 | 3 | 0 | 14 | 2 | 3 | 6 |
| Endosome | 0 | 0 | 2 | 1 | 6 | 2 | 6 | 1 | 1 | 1 | 1 | 5 | 0 | 0 | 0 | – | 4 | 1 | 0 | 2 | 3 | 0 | 2 | 2 |
| Golgi | 0 | 0 | 0 | 0 | 0 | 0 | 1 | 0 | 0 | 0 | 0 | 0 | 0 | 0 | 0 | – | 0 | 0 | 0 | 0 | 1 | 0 | 0 | 2 |
| Mitochondria | 0 | 1 | 4 | 7 | 30 | 73 | 173 | 200 | 185 | 247 | 240 | 275 | 0 | 0 | 0 | – | 14 | 8 | 1 | 1 | 11 | 8 | 8 | 12 |
| Nucleus | 2 | 1 | 2 | 1 | 1 | 2 | 1 | 3 | 4 | 2 | 1 | 1 | 0 | 0 | 1 | – | 1 | 1 | 0 | 0 | 0 | 0 | 0 | 1 |
| Nuclear Periphery | 0 | 0 | 1 | 0 | 0 | 0 | 0 | 5 | 4 | 4 | 0 | 1 | 0 | 0 | 0 | – | 0 | 0 | 0 | 0 | 1 | 0 | 0 | 0 |
| Nucleolus | 0 | 0 | 0 | 0 | 0 | 0 | 0 | 2 | 0 | 0 | 0 | 0 | 0 | 0 | 0 | – | 0 | 0 | 0 | 0 | 0 | 0 | 0 | 0 |
| Peroxisomes | 0 | 0 | 1 | 0 | 2 | 0 | 0 | 2 | 0 | 1 | 0 | 0 | 0 | 0 | 0 | – | 0 | 0 | 0 | 0 | 1 | 0 | 0 | 0 |
| SpindlePole | 3 | 0 | 1 | 0 | 8 | 0 | 3 | 8 | 3 | 5 | 0 | 6 | 0 | 0 | 0 | – | 2 | 2 | 0 | 0 | 0 | 0 | 0 | 3 |
| Vac/Vac Membrane | 0 | 0 | 0 | 1 | 7 | 1 | 3 | 8 | 4 | 3 | 1 | 3 | 0 | 0 | 0 | – | 1 | 1 | 1 | 0 | 1 | 1 | 4 | 7 |
| Unique Cell Count | 197 | 53 | 335 | 317 | 547 | 401 | 704 | 879 | 568 | 676 | 526 | 602 | 116 | 116 | 171 | 426 | 233 | 215 | 74 | 350 | 109 | 203 | 314 | |
| Labelled Cell Count | 240 | 57 | 392 | 372 | 631 | 480 | 843 | 1038 | 714 | 855 | 707 | 806 | 131 | 131 | 193 | 497 | 274 | 215 | 74 | 350 | 109 | 203 | 314 | |
Yeast GFP Assignment
Protein Abundance
| Screen | WT1 | WT2 | WT3 | RAP60 | RAP140 | RAP220 | RAP300 | RAP380 | RAP460 | RAP540 | RAP620 | RAP700 | HU80 | HU120 | HU160 | rpd3Δ_1 | rpd3Δ_2 | rpd3Δ_3 | AF100 | AF140 | AF180 |
|---|---|---|---|---|---|---|---|---|---|---|---|---|---|---|---|---|---|---|---|---|---|
| Mean Cell GFP Intensity (1e-4) | 5.3 | 4.5 | 5.0 | 5.1 | 5.0 | 4.3 | 4.0 | 4.4 | 4.1 | 3.9 | 4.0 | 4.0 | 6.1 | 6.1 | 6.2 | 4.7 | 5.2 | 6.0 | 6.9 | 6.7 | 7.0 |
| Std Deviation (1e-4) | 0.6 | 0.4 | 1.2 | 1.5 | 1.7 | 1.4 | 1.1 | 1.2 | 1.3 | 1.0 | 1.1 | 1.0 | 0.6 | 0.6 | 1.0 | 1.2 | 0.9 | 1.1 | 1.9 | 1.4 | 1.4 |
| Intensity Change (Log2) | – | – | – | 0.01 | 0.0 | -0.22 | -0.34 | -0.2 | -0.28 | -0.35 | -0.35 | -0.35 | 0.28 | 0.28 | 0.3 | -0.09 | 0.06 | 0.26 | 0.46 | 0.4 | 0.47 |
Localization Change
| Localization | RAP60 | RAP140 | RAP220 | RAP300 | RAP380 | RAP460 | RAP540 | RAP620 | RAP700 | HU80 | HU120 | HU160 | rpd3Δ_1 | rpd3Δ_2 | rpd3Δ_3 |
|---|---|---|---|---|---|---|---|---|---|---|---|---|---|---|---|
| Actin | – | – | – | – | – | – | – | – | – | – | – | – | – | – | – |
| Bud | – | – | – | – | – | – | – | – | – | – | – | – | – | – | – |
| Bud Neck | – | – | – | – | – | – | – | – | – | – | – | – | – | – | – |
| Bud Site | – | – | – | – | – | – | – | – | – | – | – | – | – | – | – |
| Cell Periphery | – | – | – | – | – | – | – | – | – | – | – | – | – | – | – |
| Cyto | – | – | – | – | – | – | – | – | – | – | – | – | – | – | – |
| Endoplasmic Reticulum | – | – | – | – | – | – | – | – | – | – | – | – | – | – | – |
| Endosome | – | – | – | – | – | – | – | – | – | – | – | – | – | – | – |
| Golgi | – | – | – | – | – | – | – | – | – | – | – | – | – | – | – |
| Mitochondria | – | – | – | – | – | – | – | – | – | – | – | – | – | – | – |
| Nuclear Periphery | – | – | – | – | – | – | – | – | – | – | – | – | – | – | – |
| Nuc | – | – | – | – | – | – | – | – | – | – | – | – | – | – | – |
| Nucleolus | – | – | – | – | – | – | – | – | – | – | – | – | – | – | – |
| Peroxisomes | – | – | – | – | – | – | – | – | – | – | – | – | – | – | – |
| SpindlePole | – | – | – | – | – | – | – | – | – | – | – | – | – | – | – |
| Vac | – | – | – | – | – | – | – | – | – | – | – | – | – | – | – |
| Cortical Patches | – | – | – | – | – | – | – | – | – | – | – | – | – | – | – |
| Cytoplasm | – | – | – | – | – | – | – | – | – | – | – | – | – | – | – |
| Nucleus | – | – | – | – | – | – | – | – | – | – | – | – | – | – | – |
| Vacuole | – | – | – | – | – | – | – | – | – | – | – | – | – | – | – |
External localization resources
Images






























Protein Concentration and Protein Localization Data
| R1 | R2 | R3 | ||||||||||||||||
|---|---|---|---|---|---|---|---|---|---|---|---|---|---|---|---|---|---|---|
| G1 Pre-START | G1 Post-START | S/G2 | Metaphase | Anaphase | Telophase | G1 Pre-START | G1 Post-START | S/G2 | Metaphase | Anaphase | Telophase | G1 Pre-START | G1 Post-START | S/G2 | Metaphase | Anaphase | Telophase | |
| Concentration | 1.3703 | 2.1319 | 1.8382 | 1.1147 | 1.3627 | 1.7532 | 0.0049 | 0.9384 | 0.6173 | 0.2645 | 0.2688 | 0.4976 | -0.1013 | 0.2374 | -0.2141 | 0.5783 | 0.1548 | -0.1439 |
| Actin | 0.0277 | 0.0067 | 0.0216 | 0.001 | 0.0024 | 0.0126 | 0.0172 | 0.0026 | 0.0579 | 0.0247 | 0.0099 | 0.0055 | 0.0525 | 0.0019 | 0.0048 | 0.0766 | 0.0046 | 0.0059 |
| Bud | 0.0012 | 0.0016 | 0.01 | 0.004 | 0.0002 | 0.0024 | 0.0099 | 0.0043 | 0.026 | 0.0155 | 0.0245 | 0.0024 | 0.0007 | 0.0003 | 0.0117 | 0.0072 | 0.0059 | 0.0005 |
| Bud Neck | 0.0022 | 0.0015 | 0.0075 | 0.0007 | 0.0007 | 0.0487 | 0.0114 | 0.0013 | 0.0019 | 0.0119 | 0.0478 | 0.0115 | 0.0012 | 0.0007 | 0.0004 | 0.0076 | 0.002 | 0.0365 |
| Bud Periphery | 0.0032 | 0.0032 | 0.0574 | 0.0099 | 0.0005 | 0.0061 | 0.0226 | 0.0138 | 0.0884 | 0.1076 | 0.0347 | 0.0053 | 0.0015 | 0.0006 | 0.0828 | 0.0663 | 0.0142 | 0.0015 |
| Bud Site | 0.0276 | 0.0326 | 0.0186 | 0.0025 | 0.0003 | 0.0031 | 0.0329 | 0.076 | 0.0274 | 0.0204 | 0.007 | 0.0006 | 0.0068 | 0.0058 | 0.0014 | 0.0029 | 0.0117 | 0.0032 |
| Cell Periphery | 0.0119 | 0.0068 | 0.0087 | 0.004 | 0.0028 | 0.0058 | 0.015 | 0.0057 | 0.0099 | 0.0067 | 0.0035 | 0.004 | 0.0071 | 0.0088 | 0.0096 | 0.0269 | 0.0016 | 0.0024 |
| Cytoplasm | 0.6812 | 0.5786 | 0.5859 | 0.7903 | 0.8095 | 0.6541 | 0.6123 | 0.5797 | 0.5213 | 0.5272 | 0.7759 | 0.7222 | 0.3929 | 0.6458 | 0.6486 | 0.549 | 0.4096 | 0.7085 |
| Cytoplasmic Foci | 0.0169 | 0.0071 | 0.011 | 0.0017 | 0.0189 | 0.019 | 0.0197 | 0.0055 | 0.0096 | 0.0109 | 0.0071 | 0.0023 | 0.0382 | 0.0024 | 0.0038 | 0.0102 | 0.0125 | 0.0094 |
| Eisosomes | 0.0007 | 0.0009 | 0.0007 | 0 | 0.0001 | 0.0003 | 0.0008 | 0.0003 | 0.0007 | 0.0002 | 0.0002 | 0.0002 | 0.0019 | 0.0015 | 0.0002 | 0.0007 | 0.0001 | 0.0006 |
| Endoplasmic Reticulum | 0.0077 | 0.0034 | 0.0038 | 0.002 | 0.0039 | 0.0026 | 0.0048 | 0.0014 | 0.0037 | 0.0022 | 0.0024 | 0.0015 | 0.0069 | 0.0037 | 0.0113 | 0.007 | 0.0018 | 0.0018 |
| Endosome | 0.0041 | 0.0021 | 0.0017 | 0.0011 | 0.0024 | 0.004 | 0.0125 | 0.0007 | 0.0049 | 0.0007 | 0.0007 | 0.0003 | 0.0084 | 0.0003 | 0.0013 | 0.0296 | 0.1028 | 0.0064 |
| Golgi | 0.0024 | 0.0007 | 0.0015 | 0.0002 | 0.0011 | 0.0016 | 0.0019 | 0.0004 | 0.0036 | 0.0006 | 0.0004 | 0.0002 | 0.0081 | 0.0003 | 0.0006 | 0.0283 | 0.0742 | 0.0065 |
| Lipid Particles | 0.0025 | 0.0004 | 0.0024 | 0.0001 | 0.0098 | 0.0039 | 0.0019 | 0.0003 | 0.0024 | 0.0002 | 0.0002 | 0.0001 | 0.0146 | 0.0005 | 0.0011 | 0.0155 | 0.0067 | 0.0023 |
| Mitochondria | 0.0003 | 0.0002 | 0.0016 | 0.0002 | 0.0003 | 0.0008 | 0.0025 | 0.0003 | 0.0124 | 0.0006 | 0.0003 | 0.0001 | 0.0419 | 0.0001 | 0.0002 | 0.0384 | 0.1477 | 0.0088 |
| None | 0.2044 | 0.3478 | 0.2531 | 0.1747 | 0.1235 | 0.2262 | 0.1973 | 0.3039 | 0.2133 | 0.2677 | 0.0815 | 0.2428 | 0.4026 | 0.3257 | 0.2177 | 0.1164 | 0.0908 | 0.1919 |
| Nuclear Periphery | 0.0005 | 0.0003 | 0.0006 | 0.0003 | 0.0003 | 0.0017 | 0.0028 | 0.0004 | 0.0009 | 0.0004 | 0.0003 | 0.0001 | 0.0008 | 0.0002 | 0.0008 | 0.0009 | 0.0016 | 0.0002 |
| Nucleolus | 0.0002 | 0.0003 | 0.0015 | 0.0001 | 0.0001 | 0.0002 | 0.0027 | 0.0003 | 0.0004 | 0.0001 | 0.0002 | 0 | 0.0004 | 0.0002 | 0.0001 | 0.0005 | 0.0021 | 0.0002 |
| Nucleus | 0.0006 | 0.0012 | 0.0015 | 0.0007 | 0.0003 | 0.0011 | 0.0056 | 0.0009 | 0.0011 | 0.0006 | 0.001 | 0.0002 | 0.0005 | 0.0003 | 0.0005 | 0.0006 | 0.0038 | 0.0004 |
| Peroxisomes | 0.0014 | 0.0002 | 0.0076 | 0 | 0.0191 | 0.0028 | 0.0176 | 0.0002 | 0.0096 | 0.0003 | 0.0002 | 0 | 0.0084 | 0 | 0 | 0.0074 | 0.0036 | 0.0114 |
| Punctate Nuclear | 0.0013 | 0.0008 | 0.0012 | 0.0001 | 0.0023 | 0.0019 | 0.003 | 0.0008 | 0.0023 | 0.0003 | 0.0005 | 0.0001 | 0.0012 | 0.0002 | 0.0003 | 0.0004 | 0.0003 | 0.0002 |
| Vacuole | 0.002 | 0.0034 | 0.0019 | 0.006 | 0.0014 | 0.001 | 0.0048 | 0.0011 | 0.0021 | 0.0011 | 0.0017 | 0.0005 | 0.0025 | 0.0007 | 0.0026 | 0.0057 | 0.084 | 0.001 |
| Vacuole Periphery | 0.0001 | 0.0001 | 0.0002 | 0.0002 | 0.0001 | 0.0002 | 0.0007 | 0.0001 | 0.0003 | 0.0001 | 0.0001 | 0 | 0.0007 | 0 | 0.0001 | 0.0019 | 0.0183 | 0.0003 |
Sequencing Data
| R1 | R2 | |||||||||
|---|---|---|---|---|---|---|---|---|---|---|
| G1 Post-START | S/G2 | Metaphase | Anaphase | Telophase | G1 Post-START | S/G2 | Metaphase | Anaphase | Telophase | |
| Gene Expression | 10.239 | 6.8199 | 8.2569 | 12.5537 | 14.5768 | 17.2562 | 13.7005 | 11.3902 | 13.937 | 16.0319 |
| Translational Efficiency | 1.6228 | 1.4591 | 1.075 | 0.9789 | 1.0525 | 1.0648 | 0.8354 | 0.9918 | 0.8111 | 0.8872 |
Hit Data
| Dataset | Hit |
|---|---|
| Protein Concentration | ✘ |
| Protein Localization | ✘ |
| Gene Expression | ✘ |
| Translational Efficiency | ✘ |
Endocytosis
| Temp | Actin Patch (Sac6-tdTomato) | Cortical Patch (Sla1-GFP) | Late Endosome (Snf7-GFP) | Vacuole (Vph1-GFP) |
|---|---|---|---|---|
| 37℃ | ||||
| RT |
Cell Cycle Omics
CYCLoPs (Zds1-GFP)
| Gene / Allele | Actin Patch (Sac6-tdTomato) | Cortical Patch (Sla1-GFP) | Late Endosome (Snf7-GFP) | Vacuole (Sac6-tdTomato) |
|---|
| Gene | Images |
|---|
| Gene | Images |
|---|
Images are not yet available
Images are not yet available